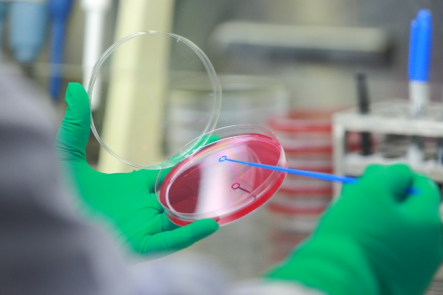

遵循GLP體系和AAALAC體系以及ICH指導(dǎo)原則,開展藥物的非臨床安全性評(píng)價(jià)。遺傳毒理實(shí)驗(yàn)室生物安全I(xiàn)I級(jí)實(shí)驗(yàn)室
 
細(xì)菌和細(xì)胞培養(yǎng)
微核檢測(cè)技術(shù)
 
|
 0731-83285167
0731-83285167
 湖南長(zhǎng)沙市國(guó)家級(jí)瀏陽經(jīng)濟(jì)技術(shù)開發(fā)區(qū)康天路123號(hào)
湖南長(zhǎng)沙市國(guó)家級(jí)瀏陽經(jīng)濟(jì)技術(shù)開發(fā)區(qū)康天路123號(hào)
 歡迎掃碼關(guān)注微信公眾號(hào)
歡迎掃碼關(guān)注微信公眾號(hào)
 湘公網(wǎng)安備43018102000584號(hào)
湘公網(wǎng)安備43018102000584號(hào)